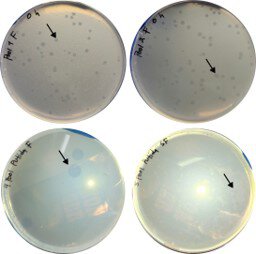

Mario Romero-Rivera, Miguel D. Fernández-de-Bobadilla, María Beltrán, Rosa del Campo, José Avendaño-Ortiz and Cristina Herencias. Genome assembly and functional predation analysis of novel Bdellovibrio isolates from human gut microbiota
Front. Microbiol. 2026
"Human-derived predatory bacteria pave the way to 'living antibiotics' that can attack multidrug-resistant pathogens while preserving the gut microbiota". - Mario Romero-Rivera and Dr. Cristina Herencias Rodríguez
Summary:
Introduction: Predatory bacteria of the Bdellovibrio and like organisms (BALOs) have long been postulated as living antimicrobials, yet their occurrence and ecological roles within human-associated microbiota have remained uncertain due to the absence of culturable human-derived isolates. Here, we report the first successful isolation and comprehensive characterization of viable Bdellovibrio bacteriovorus from human fecal samples.
Methods: Targeted enrichment was applied to five pooled fecal samples to facilitate predator recovery. We performed whole-genome sequencing on the isolates and conducted comparative genomics across 162 publicly available Bdellovibrio genomes. Additionally, pangenome analysis of 22 high-quality genomes and phenotypic assays against clinical pathogens were conducted to assess genomic diversity, prey specificity, and biosafety profiles.
Results: Despite extremely low natural abundance, targeted enrichment recovered predators in two of five pooled samples, which produced characteristic lytic plaques. Sequencing revealed >99% average nucleotide identity to reference strain HD100 with only 26 core single-nucleotide polymorphisms across both isolates, indicating minimal divergence between human-associated and environmental lineages. Comparative genomics showed that only 10.4% of public genomes fulfill criteria for B. bacteriovorus sensu stricto. Pangenome analysis revealed a stable, highly conserved core (~2,500-2,650 genes) and an expanding accessory genome. Phenotypically, the human-derived isolates displayed narrower prey ranges concentrated on Pseudomonas spp., including multidrug-resistant clinical strains, and no acquired virulence factors were detected.
Discussion: Collectively, these findings suggest predation in the human gut and that viable Bdellovibrio could be natural, genomically conserved members of the intestinal ecosystem. This work advances a testable keystone-predator framework for human microbiome ecology and opens an ecologically informed therapeutic pathway in which human-associated Bdellovibrio may help control multidrug-resistant pathogens while supporting microbiota homeostasis.
Why do you highligth this publication?
This study reports the first successful isolation and in-depth genomic and functional characterization of viable Bdellovibrio bacteriovorus from the human gut, closing a long-standing gap between molecular detection and true cultivation of these predatory bacteria. The human-derived isolates are almost identical at the genomic level to the classical HD100 reference strain and do not harbour acquired virulence determinants, supporting a favorable biosafety profile. Functionally, they preferentially prey on Pseudomonas spp., including multidrug-resistant clinical isolates, highlighting their potential as "living antibiotics" that can selectively target problematic pathogens. Overall, this work introduces a keystone-predator framework for understanding human microbiome ecology and opens an ecologically informed therapeutic avenue to control Gram-negative infections while helping preserve intestinal homeostasis.
Publication commented by:
Mario Romero-Rivera & Dr. Cristina Herencias Rodríguez
BIOLOGY AND EVOLUTION OF MICROORGANISMS. IRYCIS